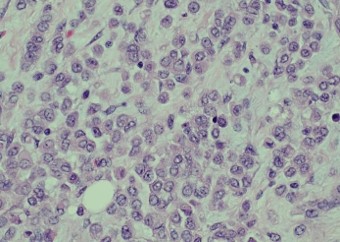

Background
Breast cancer is one of the most common malignancies among women worldwide, its annual incidence at 1,300,000 and accounting for 465,000 deaths annually [1]. Most of the breast cancer-related mortality are often secondary to distant metastasis. The incidence of primary metastasis (distant metastasis present upon presentation) and secondary metastasis (metastasis in those who have already received definitive treatment) are quoted at 4.1-8.5% and up to 30%, respectively [2].
Most common locations for distant metastasis for breast cancer include the bones, lungs, liver and brain. Here we report a rare case of secondary colonic metastasis of invasive ductal carcinoma or breast that spread to the colonic mucosa, at two years after curative intent partial mastectomy and axillary dissection, causing intestinal obstruction.
Case presentation
A 57-year-old lady was diagnosed with biopsy-proven carcinoma of the right breast. The pre-operative Positron Emission Tomography-Computed Tomography (PET-CT) of the whole body revealed no distant metastasis. The patient subsequently underwent right partial mastectomy with axillary dissection in June 2022. The pathology report was a pT2N1a intraductal carcinoma, grade 2, with no evidence of Lymphovascular Invasion (LVI-) or Perineural Invasion (PNI-); the tumour was estrogen receptor positive with an Allred score of 8 (ER+ AS8) and Progesterone Receptor positive with an Allred Score of 7 (PR+AS7), HER-2-negative, and had a Ki67 proliferation index of 35%, indicating a moderately high level of cellular activity. The Oncotype DX test revealed a recurrence score of 23, putting the patient in the intermediate risk category. The patient then underwent 25 fractions of intensity-modulated radiation therapy and was put on letrozole and adjuvant abemaciclib.
The patient was emergently admitted in February 2025 for intestinal obstruction. Urgent contrast Computed Tomography (CT) showed an irregular circumferential mural thickening at the proximal transverse colon, spanning 5.9 cm in length; a prominent adjacent pericolic lymph node was noted. She was treated as primary colorectal cancer with intestinal obstruction. Emergency open right hemicolectomy was performed. Intraoperatively there were no evidence of peritoneal metastases; there was a proximal transverse colon obstructing tumour with upstream dilatation of bowel, agreeing with the CT findings.
Pathology of the right hemicolectomy specimen was “involvement by metastatic carcinoma, immunoprofile compatible with breast primary”. The cytokeratin profile was CK7+, GATA3+ and MOC-31+, and negative for CK20 and CDX-2. There was very focal positivity for E-cadherin, while p120 catenin mostly showed cytoplasmic staining in the tumour cells. Microscopic examination suggested that the tumour invaded from mucosal side of the intestinal towards the serosa; the proximal and distal resection margins were clear. The morphology and immunoprofile point towards a metastatic carcinoma of breast.
The patient subsequently underwent whole body PET-CT at one-month post-op, which showed multiple new peritoneal, lymph node, bone, and adrenal metastases. The patient was transitioned to palliative care.
Discussion
Up to 30% of breast cancer cases present with secondary metastases. Most of the distant metastases were in the bones, lungs, liver and brain. True colonic metastases (in contrast to peritoneal deposits on colonic serosa) were rare; the rate of metastasis to the gastrointestinal tract was previously reported to be approximately 1.1% for invasive ductal carcinoma and 4.5% for invasive lobular carcinoma [3]. The differentiation between colonic metastasis of breast cancer vs primary colorectal carcinoma presents diagnostic challenges pre-operatively. But in either scenario, surgical resection with curative intention should be pursued given that the patient has reasonably good past health and pre-operative imaging demonstrated a locoregional disease.
References
- Kamangar F, Dores GM, Anderson WF. Patterns of cancer incidence, mortality, and prevalence across five continents: defining priorities to reduce cancer disparities in different geographic regions of the world. J Clin Oncol. 2006; 24: 2137-2150.
- Andre F, Slimane K, Bachelot T, Dunant A, Namer M, Barrelier A, et al. Breast cancer with synchronous metastases: trends in survival during a 14-year period. J Clin Oncol. 2004; 22: 3302-3308.
- Arpino G, Bardou VJ, Clark GM, Elledge RM. Infiltrating lobular carcinoma of the breast: tumor characteristics and clinical outcome. Breast Cancer Res. 2004; 6: 1-8.